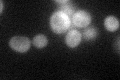
YLR200W
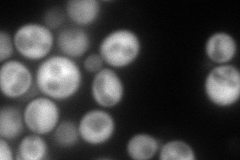
YLR200W
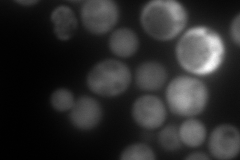
YLR200W
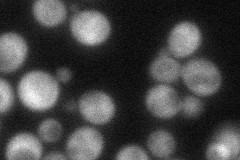
YLR200W
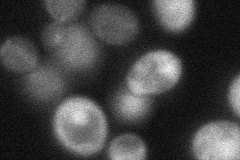
YLR200W
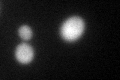
YLR200W
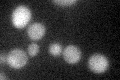
YLR200W

View description
Subunit of the heterohexameric Gim/prefoldin protein complex involved in the folding of alpha-tubulin, beta-tubulin, and actin
Localization:
Intensity:
Fold change:
Significance:
-
C’ GFP library in SD
cytosol37.84 -
N' NOP1pr-GFP in SD
cytosol176.42 -
N' TEF2pr-mCherry in SD
cytosol312.589 -
N' NATIVEpr-GFP in SD
cytosol67.7957 -
N' TEF2pr-VC and Cyto-VN in SD
cytosol64.9375 -
C’ GFP library in SD+DTT
cytosol46.961.24No -
C’ GFP library in SD+H2O2

cytosol47.461.25No -
C’ GFP library in Starvation Media
cytosol38.151No -
C’ GFP library on the background of Pup2-DaMP

cytosol -
C’ GFP library on the background of CCT mutant

cytosol28.28630.747432No
